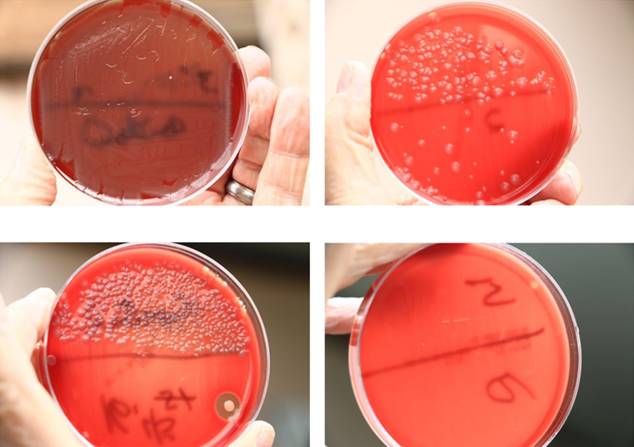

文/菱角
想舔一舔果冻吗?

美味吧......

常言马桶藏污纳垢,毕竟是固液交汇处。
但不经历舔厕,难称得上职业吃货。

(猫有什么错?)
体验前,不妨装上这个 IllumiBowl 马桶杀菌夜灯。

顾名思义,它放出的死亡光波能击灭细菌。

就像这样,细菌真菌全家死光光。

(示意图)
好刺眼的光线!

来自这个发光二极管。

IllumiBowl的这个小灯泡每 2分钟会发出 15秒 470纳米波长的光波,大部分细菌暴露在这种光波下 6分钟,就难逃一命了。
下面这个小实验清楚表明细菌宝宝们悲惨的死亡过程。
(对不起密集恐惧症患者啊)
该技术一开始在医院中被发明应用,而且有大量学术研究已证明其效果。

点击打开这篇《470 纳米蓝光能有效抑制细菌和真菌生长》。

再点击打开《蓝光光线疗法杀死抗药性细菌》。
小的研究了几天几夜,觉得靠谱!于是决定安利这款产品。

看我找了那么多资料,信了吧?

下面我们再来看其他特性。
IllumiBowl 非常智能,白天很亮所以绝对不会亮。

即时在夜晚,为了省电,无人时也是暗的(但不影响它的杀菌效果),只要检测到人的脚步,自动亮起。

3种亮度随意调节。建议选择柔和的光线,以免半夜如厕时被强光闪瞎。

由于采用了记忆材料,它可以轻松掰弯,挂在任意马桶边缘。

最新款采用了 5 号电池。

电池能顶 4-6 个月。

多达 8种颜色供你挑选,可设置自动变换或者单色。

还有很重要的一点是——不俗的防水能力,水花飞溅、水汽黏着都不会影响它的功能。

部件包括伸入马桶内的灯,马桶外面的电源、感应器。

该产品在 2014 年开始众筹,发展至今已是第三代,众筹总金额已经突破 40 万美元。
产品在电量、感应方面不断做出改进,质量稳定,逐渐被摆上了沃尔玛等大小超市的货架。

并且上了美国广播公司的 SHARK TANK发明创业秀。

但对于中国家庭有一个致命问题——蹲厕!怎么办?

凉拌吧。
但不管怎样,创次方的菌菌们是杀不死的。



评论